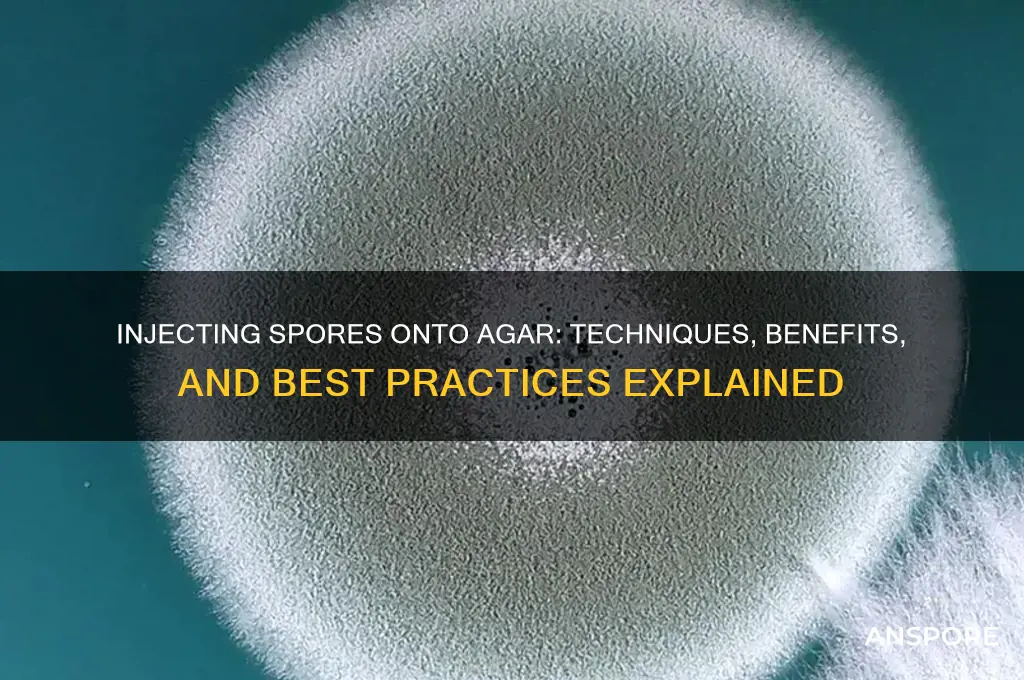
can you inject spores onto agar

Injecting spores onto agar is a common technique used in microbiology and mycology to cultivate fungi and bacteria in a controlled laboratory environment. This method involves carefully introducing a small amount of spore suspension into a sterile agar medium, typically using a syringe or other precision tool. The agar provides essential nutrients and a solid substrate for the spores to germinate and grow, allowing researchers to study microbial colonies, identify species, or produce cultures for further experimentation. Proper sterilization and aseptic techniques are crucial to prevent contamination and ensure accurate results. This process is widely applied in fields such as biotechnology, medicine, and environmental science for purposes ranging from antibiotic discovery to fungal taxonomy.
| Characteristics | Values |
|---|---|
| Method | Injecting spores onto agar |
| Purpose | To cultivate fungi or bacteria from spores for identification, research, or cultivation |
| Agar Type | Typically Potato Dextrose Agar (PDA) or other nutrient-rich media suitable for fungal/bacterial growth |
| Sterility | Agar must be sterile to prevent contamination |
| Injection Tool | Sterile syringe or inoculation loop |
| Spores Source | Spores can be collected from mature fungal structures (e.g., mushrooms, molds) or bacterial cultures |
| Viability | Spores must be viable to germinate and grow on agar |
| Incubation | Agar plates are incubated at optimal temperature (e.g., 25°C for fungi) for several days |
| Contamination Risk | High if aseptic techniques are not followed |
| Applications | Mycology, microbiology, biotechnology, and environmental studies |
| Advantages | Allows for isolation and study of specific spore-producing organisms |
| Limitations | Requires sterile conditions and proper handling to avoid contamination |
| Alternative Methods | Surface plating, spore suspension spreading, or direct inoculation with a sterile loop |
Explore related products
What You'll Learn
- Sterile Technique: Maintaining cleanliness to prevent contamination during spore injection
- Spore Suspension: Preparing a concentrated solution of spores for injection
- Agar Preparation: Properly sterilizing and cooling agar plates before use
- Injection Tools: Using sterile needles or syringes for precise spore delivery
- Incubation Conditions: Optimal temperature and humidity for spore germination on agar

Sterile Technique: Maintaining cleanliness to prevent contamination during spore injection
Injecting spores onto agar requires precision and sterility to ensure the culture’s integrity. Even a single contaminant can compromise the entire experiment, rendering hours of work useless. Sterile technique is not just a practice but a mindset, demanding meticulous attention to detail at every step. From the moment you prepare your workspace to the final sealing of the Petri dish, every action must prioritize cleanliness. This is particularly critical when handling spores, which are resilient and can easily be overshadowed by faster-growing contaminants like bacteria or mold.
To begin, sterilize all equipment—needles, syringes, and agar plates—using an autoclave at 121°C for 15–20 minutes. Flame sterilization is an alternative for metal tools, but it’s less reliable for complex surfaces. Work in a laminar flow hood if available, as it provides a HEPA-filtered environment that minimizes airborne particles. If a hood isn’t accessible, create a makeshift sterile field by wiping down surfaces with 70% ethanol and allowing them to dry completely. Always wear sterile gloves and a lab coat, and avoid touching non-sterile surfaces during the procedure.
The injection process itself demands a steady hand and deliberate movements. First, flame the neck of the spore vial and the needle before withdrawing the spore suspension to eliminate surface contaminants. Insert the needle through the agar’s surface at a 45-degree angle, depositing a small droplet (0.1–0.2 mL) just below the agar’s surface. Avoid puncturing the agar too deeply, as this can create channels for contamination. After injection, flame the needle again before recapping to prevent airborne particles from settling on the tip.
Contamination risks often arise from overlooked details. For instance, failing to properly seal the Petri dish or leaving it exposed for too long can introduce contaminants. Always incubate plates upside down to prevent condensation from dripping onto the agar surface. Regularly inspect your workspace for potential sources of contamination, such as open windows or cluttered surfaces. Even the slightest lapse in sterile technique can lead to failed cultures, so consistency and vigilance are key.
Mastering sterile technique for spore injection is both an art and a science. It requires practice, patience, and a deep understanding of microbial behavior. By adhering to these principles, you not only protect your experiment but also cultivate a habit of precision that benefits all laboratory work. Remember, the goal isn’t just to avoid contamination—it’s to create an environment where your spores can thrive uncontested.
UV Light's Power: Can It Destroy Bacterial Spores Effectively?
You may want to see also

Spore Suspension: Preparing a concentrated solution of spores for injection
Injecting a spore suspension onto agar is a precise technique used in microbiology to cultivate fungi or bacteria under controlled conditions. The process begins with preparing a concentrated solution of spores, ensuring uniformity and viability for accurate experimental results. To create a spore suspension, start by selecting a mature fungal culture or bacterial source rich in spores. Gently scrape the surface of the culture using a sterile tool, such as a scalpel or spatula, to dislodge the spores without damaging them. Transfer the collected material into a sterile tube containing a small volume of distilled water or a buffer solution, typically 1–2 mL, to maintain spore integrity.
Next, vortex or manually agitate the suspension to disperse the spores evenly. For enhanced precision, filter the suspension through a sterile mesh or gauze to remove debris, ensuring only spores remain. Adjust the concentration by diluting or concentrating the solution based on experimental needs. A common target concentration is 10^6 to 10^8 spores per mL, verified using a hemocytometer or spectrophotometer. Label the suspension with details like the organism, concentration, and preparation date for traceability.
When injecting the spore suspension onto agar, use a sterile syringe with a fine needle (e.g., 27–30 gauge) to minimize disruption of the agar surface. Inject 10–50 μL of the suspension at a slight angle, creating a small well or streak, depending on the desired inoculation method. Avoid over-injection, as it can lead to uneven growth or contamination. Flame-sterilize the needle between injections if multiple samples are being processed.
Caution must be exercised to prevent contamination during preparation and injection. Work in a sterile environment, such as a biosafety cabinet, and use autoclaved equipment. Store the spore suspension at 4°C for short-term use or freeze at -20°C with a cryoprotectant like glycerol for long-term preservation. Regularly assess spore viability post-thaw to ensure experimental reliability.
In summary, preparing and injecting a spore suspension onto agar requires attention to detail, sterility, and precision. By following these steps, researchers can achieve consistent and reproducible results in fungal or bacterial cultivation, laying the foundation for successful microbiological studies.
How Ferns Disperse Spores: Unveiling the Ancient Reproduction Process
You may want to see also

Agar Preparation: Properly sterilizing and cooling agar plates before use
Sterilization is the cornerstone of successful agar preparation, ensuring that the medium remains free from contaminants that could interfere with spore injection and subsequent growth. Autoclaving is the gold standard for this process, subjecting the agar to high-pressure steam at 121°C for 15–20 minutes. This eliminates bacteria, fungi, and other microorganisms, creating a sterile environment essential for accurate results. Always ensure the autoclave reaches the correct temperature and pressure, as insufficient sterilization can lead to unreliable outcomes. After autoclaving, allow the agar to cool slightly before pouring it into Petri dishes in a sterile laminar flow hood to minimize airborne contamination.
Cooling agar plates properly is equally critical, as improper handling can introduce impurities or damage the agar’s structure. Once poured, let the plates solidify at room temperature for 30–45 minutes, avoiding refrigeration or rapid cooling, which can cause condensation and compromise sterility. Condensation droplets on the lid can drip onto the agar surface, potentially introducing contaminants. If time is a constraint, place the plates in a sterile environment with controlled airflow to expedite cooling without risking contamination. Properly cooled plates should have a clear, even surface, ready for spore injection.
When injecting spores onto agar, the timing of plate usage is crucial. Allow the agar to cool completely but use the plates within 24–48 hours of preparation for optimal results. Over time, the agar’s pH and moisture content can shift, affecting spore germination and growth. Label plates with preparation dates to track freshness. For long-term storage, seal plates in plastic bags and refrigerate at 4°C, though this may alter the agar’s properties slightly. Always inspect plates before use, discarding any with signs of contamination or drying.
Practical tips can streamline the agar preparation process. Use pre-sterilized Petri dishes to save time and reduce contamination risks. If preparing multiple plates, work in batches, pouring agar into a subset of dishes at a time to maintain control over cooling. Keep the laminar flow hood clean and turned on for at least 10 minutes before use to ensure a sterile workspace. When injecting spores, use a sterile inoculation loop or syringe, flame-sterilizing the loop between samples to prevent cross-contamination. These steps, when executed meticulously, ensure that agar plates provide a reliable foundation for spore injection and cultivation.
Do Plants Produce Spores Through Meiosis? Unraveling the Process
You may want to see also
Explore related products

Injection Tools: Using sterile needles or syringes for precise spore delivery
Sterile needles and syringes offer a precise, controlled method for delivering spores onto agar, making them invaluable tools in mycology and microbiology. Unlike spore suspension pouring or streaking, injection allows for targeted placement, minimizing contamination risks and enabling the study of specific spore behaviors. This technique is particularly useful when working with limited spore quantities or when isolating individual spores for genetic analysis.
A 25-gauge or smaller needle is ideal for this purpose, as its fine tip minimizes agar damage while ensuring accurate spore deposition.
Mastering the injection technique requires practice and attention to detail. Begin by preparing a spore suspension with a concentration of 10^6 spores per mL for optimal results. Draw a small volume (0.1-0.2 mL) into the syringe, ensuring no air bubbles are present. Gently insert the needle through the agar surface at a 45-degree angle, releasing a single droplet (approximately 0.01 mL) at the desired location. Withdraw the needle slowly to avoid agar disruption. This method allows for the creation of precise spore grids or patterns, facilitating experiments requiring spatial control.
For instance, researchers studying fungal interactions can position spores of different species at specific distances to observe growth dynamics.
While sterile needles and syringes provide unparalleled precision, they demand strict aseptic technique. Autoclaving or flame-sterilizing the needle before and after each use is crucial to prevent cross-contamination. Additionally, working in a laminar flow hood significantly reduces the risk of airborne contaminants. It's essential to handle the syringe with care, avoiding excessive pressure that could damage the agar or disperse spores uncontrollably.
The advantages of injection tools extend beyond precision. This method enables the study of spore germination and growth under various conditions, such as nutrient gradients or pH variations, by allowing for localized agar modifications. Furthermore, the ability to place spores at specific depths within the agar provides insights into the influence of oxygen availability on fungal development. By combining injection techniques with time-lapse microscopy, researchers can capture the intricate process of spore germination and hyphal extension with remarkable clarity.
In conclusion, sterile needles and syringes are powerful instruments for precise spore delivery onto agar, offering mycologists and microbiologists a level of control unparalleled by other methods. With careful technique and attention to sterility, researchers can unlock new avenues of study, from fungal interactions to spore germination dynamics. As with any laboratory technique, practice and adherence to best practices are key to harnessing the full potential of injection tools in agar-based experiments.
Are All Spore-Forming Bacteria Gram-Positive? Unraveling the Myth
You may want to see also

Incubation Conditions: Optimal temperature and humidity for spore germination on agar
Spores, when introduced onto agar, require precise incubation conditions to germinate successfully. Temperature plays a pivotal role, with most fungal spores thriving between 25°C and 30°C (77°F to 86°F). This range mimics their natural environment, encouraging metabolic activation without causing stress. For bacterial spores, such as those from *Bacillus* species, temperatures around 37°C (98.6°F) are often optimal, aligning with their mesophilic nature. Deviating from these ranges can delay germination or render spores dormant, underscoring the need for species-specific calibration.
Humidity is equally critical, as spores require moisture to initiate metabolic processes. Agar plates should be sealed to maintain a relative humidity of 90–95%, preventing desiccation. This can be achieved using airtight containers or plastic wrap, ensuring the agar surface remains moist. Low humidity levels can halt germination, while excessive moisture may promote contamination. Striking this balance is essential for consistent results, particularly in laboratory settings where precision is paramount.
Incubation duration varies depending on the spore type and conditions. Fungal spores typically germinate within 24–48 hours under optimal temperature and humidity, while bacterial spores may take 12–24 hours. Observing early signs of germination, such as swelling or the emergence of hyphae, can help fine-tune incubation times. Regular monitoring is advisable to prevent over-incubation, which can lead to overcrowding or secondary growth phases.
Practical tips include pre-warming agar plates to the desired temperature before inoculation, ensuring spores are evenly distributed, and avoiding direct exposure to light, which can inhibit germination in some species. For long-term storage, spores can be maintained in a desiccated state at 4°C (39°F), reactivating them upon reintroduction to optimal conditions. Mastery of these incubation parameters transforms spore germination from an art to a science, enabling reliable cultivation for research, agriculture, or industrial applications.
Boiling Water: Effective Method to Kill Spores or Not?
You may want to see also
Frequently asked questions
Yes, you can inject spores directly onto agar using a sterile syringe or inoculation loop. Ensure all equipment is properly sterilized to avoid contamination.
The best method is to use a sterile syringe or inoculation loop. Flame-sterilize the needle or loop, cool it briefly, and then gently inject or streak the spores onto the agar surface.
Yes, the syringe must be sterilized before use. Flame-sterilize the needle by passing it through a bunsen burner flame until it glows red, then allow it to cool before injecting the spores.
Yes, if the equipment or environment is not sterile, injecting spores can introduce contaminants. Always work in a sterile environment, such as a laminar flow hood, and use properly sterilized tools.

























